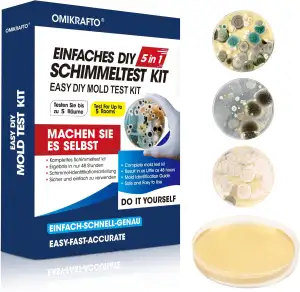
Schimmeltest Kit für ZuHause - Schimmelpilz Test für 5 Räume - Schimmelpilz Schn

Die unsichtbare Gefahr: Warum Feinstaub so problematisch ist
Moderne Haushaltsroboter haben unser Leben revolutioniert. Sie saugen, wischen und machen unser Zuhause sauber, während wir uns anderen Dingen widmen können. Doch während die Böden makellos erscheinen, stellt sich eine wichtige Frage: Was passiert mit der Luftqualität in unseren vier Wänden? Insbesondere Feinstaub ist eine unsichtbare Bedrohung, die oft unterschätzt wird. Diese winzigen Partikel, die kleiner als ein menschliches Haar sind, können tief in unsere Atemwege eindringen und dort gesundheitliche Probleme verursachen. Allergene wie Pollen, Milbenkot, Tierhaare sowie Bakterien und Viren sind oft an diese Feinstaubpartikel gebunden. Ein herkömmlicher Staubsauger, ob manuell oder als Roboter, kann diese Partikel aufwirbeln und im schlimmsten Fall sogar wieder in den Raum blasen, wenn sein Filtersystem nicht ausreichend ist. Hier kommt die entscheidende Rolle von HEPA Filter Saugroboter ins Spiel, die nicht nur den Boden reinigen, sondern auch aktiv zur Verbesserung der Raumluft beitragen.
Empfohlene Produkte zu HEPA Filter Ersatz Saugroboter

13 Stück Zubehör für Dreame L10s Ultra/Xiaomi X10 Saugroboter Ersatzteile, Haupt

HomeTimes Ersatzteile für Philips Homerun Serie 2000 3000 XU3100/01 XU3110/02 XU

10 Stück HEPA-Filter für ILIFE V3, V3S, V3S Pro, V5, V5S, V5S Pro Staubsauger Er

HEPA-Filter für AIRROBO für P20 Saugroboter, 4er-Pack, Ersatz, hochfestes, wasch
* Affiliate-Links
Was ist ein HEPA Filter Saugroboter? Funktionsweise und Vorteile
HEPA steht für „High Efficiency Particulate Air“ und bezeichnet einen speziellen Filtertyp, der in der Lage ist, selbst kleinste Partikel aus der Luft zu filtern. Ursprünglich für medizinische und industrielle Anwendungen entwickelt, finden diese Hochleistungsfilter heute zunehmend ihren Weg in Haushaltsgeräte, insbesondere in Staubsaugerroboter. Ein HEPA Filter Saugroboter arbeitet nach einem einfachen, aber hochwirksamen Prinzip: Die angesaugte Luft wird durch ein feines Netz aus Fasern geleitet. Dabei werden Partikel nicht nur mechanisch zurückgehalten, sondern auch durch Trägheit, Diffusion und den sogenannten Sperreffekt eingefangen. Dies ermöglicht es, Partikel mit einer Größe von nur 0,3 Mikrometern und mehr mit einer Effizienz von mindestens 99,95 % (nach europäischer Norm EN 1822) oder sogar 99,97 % (nach US-Norm) abzuscheiden. Das bedeutet, dass Allergene, Bakterien, Viren und selbst kleinste Staubpartikel effektiv aus der Luft entfernt werden, bevor die gereinigte Luft wieder in den Raum abgegeben wird.
Die Vorteile eines solchen Filtersystems sind vielfältig. Neben der offensichtlichen Verbesserung der Hygiene in Ihrem Zuhause trägt ein HEPA Filter Saugroboter maßgeblich zu einer besseren Luftqualität Zuhause bei. Dies ist besonders relevant für sensible Personengruppen, aber auch für alle, die Wert auf ein gesundes Wohnklima legen.
Empfohlene Produkte zu Luftqualität Zuhause

Schimmeltest Kit für ZuHause - Schimmelpilz Test für 5 Räume - Schimmelpilz Schn

SwitchBot CO2-Melder, CO2 Messgerät mit Thermometer Hygrometer Innen, Luftqualit

Temtop C1 CO₂ Messgerät mit CO2-Monitor, Thermometer & Hygrometer – Präzise Mess

Temtop RaumLuftqualitätsdetektor Luftqualitätsdetektor Innenraum Monitor Datenau
* Affiliate-Links
HEPA Filter Saugroboter: Ein Muss für Allergiker und Asthmatiker
Für Millionen von Menschen weltweit sind Allergien und Asthma eine tägliche Belastung. Hausstaubmilben, Pollen, Tierhaare und Schimmelsporen sind die häufigsten Auslöser für allergische Reaktionen und können Asthmaanfälle provozieren. In Innenräumen sammeln sich diese Allergene besonders leicht an und werden durch normale Aktivitäten, wie das Gehen oder Staubsaugen mit unzureichenden Filtern, immer wieder aufgewirbelt. Ein HEPA Filter Saugroboter bietet hier einen entscheidenden Vorteil. Indem er diese mikroskopisch kleinen Partikel zuverlässig aus der Luft entfernt, reduziert er die Allergenbelastung im Raum erheblich.
Stellen Sie sich vor, Ihr Zuhause wird nicht nur von sichtbarem Schmutz befreit, sondern auch von den unsichtbaren Übeltätern, die Ihre Atemwege reizen. Viele hochwertige Modelle sind speziell darauf ausgelegt, die Bedürfnisse von Allergikern zu erfüllen. Sie verfügen oft über zusätzliche Funktionen wie eine dichte Gehäusekonstruktion, die das Austreten von ungefilterter Luft verhindert, und eine effiziente Bürstentechnologie, die tief sitzende Allergene aus Teppichen löst. Die Investition in einen Saugroboter Allergiker mit HEPA-Filter kann die Lebensqualität von Betroffenen signifikant verbessern und zu erholsameren Nächten und einem beschwerdefreieren Alltag führen.
Empfohlene Produkte zu Saugroboter Allergiker

MONSGA Saugroboter mit Wischfunktion, 3.5L Staubsauger Roboter mit Absaugstation

Saugroboter, Bürstenloses Design Staubsauger Roboter, Starkes Saugen, Selbstlade

roborock Q7 M5 Saugroboter mit Wischfunktion, 10.000Pa Starker Saugkraft, Dual A

roborock Q7 L5+ Saugroboter mit Wischfunktion, Automatischer Staubentleerung, Du
* Affiliate-Links
Jenseits der Staubwolke: Verbesserte Luftqualität für alle
Auch wenn Sie nicht direkt von Allergien oder Asthma betroffen sind, profitieren Sie von der verbesserten Luftqualität, die ein HEPA Filter Saugroboter mit sich bringt. Eine geringere Feinstaubbelastung bedeutet weniger Reizungen der Atemwege, weniger Staub auf Möbeln und Oberflächen und ein insgesamt frischeres Raumklima. Besonders in städtischen Gebieten, wo die Außenluft oft bereits mit Schadstoffen belastet ist, wird die Bedeutung einer sauberen Innenraumluft immer größer. Ein Roboter, der kontinuierlich die Luft reinigt, ist eine wertvolle Ergänzung für jedes Smart Home, das auf Gesundheit und Wohlbefinden seiner Bewohner abzielt. Ergänzend dazu können auch andere Smart Home Geräte zur Luftverbesserung beitragen, wie ein Luftfeuchter Smart Home, um ein optimales Raumklima zu schaffen. Wer die Luftqualität genau überwachen möchte, findet in einem Feinstaubmessgerät Innenraum ein nützliches Werkzeug.
Empfohlene Produkte zu Feinstaubmessgerät Innenraum

Tragbarer Luftqualitätstester, Smart Air Quality Monitor für Zuhause & Büro, prä

PM2.5 Detektor mit Smart-App, Luftqualität Messgerät mit Alarm und Aufzeichnung,

Laserliner Feinstaubmessgerät, Luftqualität Messgerät für Pollen und Allergene,
* Affiliate-Links
Wartung und Pflege: So bleibt Ihr HEPA Filter Saugroboter effizient
Damit Ihr HEPA Filter Saugroboter seine volle Leistungsfähigkeit behält und die Luft in Ihrem Zuhause zuverlässig reinigt, ist regelmäßige Wartung unerlässlich. Der HEPA-Filter ist ein Verschleißteil und muss in bestimmten Intervallen gereinigt und ausgetauscht werden. Die genauen Intervalle hängen von der Nutzungshäufigkeit, der Größe des Haushalts und dem Grad der Verschmutzung ab. In der Regel empfehlen die Hersteller, den Filter alle 1 bis 3 Monate zu wechseln. Einige Filter lassen sich unter fließendem Wasser reinigen, andere sind nur für die Trockenreinigung mit einem Filterreinigungspinsel geeignet. Achten Sie stets auf die spezifischen Anweisungen des Herstellers.
Eine regelmäßige Reinigung des Filters ist entscheidend, um die Saugleistung des Roboters aufrechtzuerhalten und eine optimale Filterwirkung zu gewährleisten. Ein verstopfter Filter reduziert nicht nur die Effizienz, sondern kann auch den Motor des Geräts überlasten und dessen Lebensdauer verkürzen. Viele Hersteller bieten praktische Staubsaugerroboter Wartungskit an, die neben Ersatzfiltern oft auch neue Seitenbürsten und Hauptbürsten enthalten, um die gesamte Reinigungsleistung des Roboters zu optimieren.
Empfohlene Produkte zu Staubsaugerroboter Wartungskit

dreame L10s Ultra Gen 2 Saugroboter mit Wischfunktion,MopExtend™ RoboSwing-Techn

eufy Saugroboter mit Wischfunktion C28, HydroJet selbstreinigende Wischrolle, 15

Bosch Spotless + BCRD1W Saugroboter mit Wischfunktion, 11.000 Pa Saugkraft, Wisc
* Affiliate-Links
Wann sollte der HEPA Filter Saugroboter gewechselt werden?
Die Lebensdauer eines HEPA-Filters hängt stark von der Umgebung ab. In Haushalten mit Haustieren, Rauchern oder hohem Pollenaufkommen kann ein häufigerer Wechsel notwendig sein. Anzeichen für einen fälligen Filterwechsel sind eine spürbar nachlassende Saugleistung, ein unangenehmer Geruch, der aus dem Roboter kommt, oder eine sichtbare Verfärbung und Verstopfung des Filters. Ignorieren Sie diese Anzeichen nicht, denn ein alter, verstopfter Filter kann seine Funktion nicht mehr erfüllen und sogar die Luftqualität verschlechtern, indem er gefilterte Partikel wieder abgibt. Halten Sie immer einen Vorrat an HEPA Filter Ersatz Saugroboter bereit, um einen reibungslosen Austausch zu gewährleisten.
Fazit: Eine Investition in Gesundheit und Komfort
Die Entscheidung für einen HEPA Filter Saugroboter ist mehr als nur eine Wahl für ein weiteres Smart-Home-Gerät; es ist eine Investition in die Gesundheit und das Wohlbefinden Ihrer Familie. Diese intelligenten Helfer entlasten nicht nur im Alltag, sondern tragen aktiv dazu bei, die Luftqualität in Ihrem Zuhause signifikant zu verbessern. Insbesondere für Allergiker und Asthmatiker sind sie eine unverzichtbare Unterstützung, um die Belastung durch Allergene zu minimieren. Doch auch alle anderen profitieren von einer saubereren, frischeren Raumluft und einem gesünderen Wohnklima. Achten Sie beim Kauf auf Modelle, die über zertifizierte HEPA-Filter verfügen und berücksichtigen Sie die empfohlenen Wartungsintervalle, um die volle Leistungsfähigkeit des Geräts dauerhaft zu erhalten. So genießen Sie nicht nur saubere Böden, sondern auch eine spürbar bessere Atemluft – Tag für Tag, ganz automatisch.
Häufig gestellte Fragen
Was sind HEPA-Filter und warum sind sie wichtig für Saugroboter?
HEPA steht für "High Efficiency Particulate Air" und bezeichnet einen speziellen Typ von Luftfiltern, die über eine extrem hohe Abscheideleistung verfügen. Diese Filter sind in der Lage, selbst winzigste Partikel aus der Luft zu entfernen, die für das menschliche Auge unsichtbar sind. In Saugrobotern spielen HEPA-Filter eine entscheidende Rolle, da sie nicht nur groben Schmutz vom Boden aufnehmen, sondern auch verhindern, dass der feine Staub, der beim Saugvorgang aufgewirbelt wird, wieder in die Raumluft gelangt.
Ohne einen effektiven Filter würden Saugroboter zwar den Boden reinigen, aber gleichzeitig die Luft mit Allergenen, Pollen, Milbenkot, Schimmelsporen und Feinstaub belasten. Ein hochwertiger HEPA-Filter für Saugroboter fängt diese Partikel zuverlässig ab und sorgt so dafür, dass die ausgeblasene Luft deutlich sauberer ist. Dies ist besonders vorteilhaft für Allergiker, Asthmatiker und alle, die Wert auf eine gesunde Raumluft legen. Durch den Einsatz solcher Filter wird die Gesamtluftqualität im Wohnraum merklich verbessert und das Risiko von Atemwegsbeschwerden reduziert.
Empfohlene Produkte zu hepa filter saugroboter

MONSGA Saugroboter mit Wischfunktion, 3.5L Staubsauger Roboter mit Absaugstation

Saugroboter mit Wischfunktion 5000Pa, Staubsauger Roboter 3 in 1 mit 180Min Lauf

dreame D20 Pro Plus Saugroboter, 13.000 Pa Saugkraft, DuoBrush für Tierhaare, Ec

Spino E1 Poolroboter Akku Boden und Wand, 210 Min Kabellos Poolsauger, Max 21950
* Affiliate-Links
Wie oft sollte man den HEPA-Filter im Saugroboter wechseln?
Die Häufigkeit des Filterwechsels hängt von mehreren Faktoren ab, darunter die Nutzungsintensität des Saugroboters, die Größe des Haushalts, das Vorhandensein von Haustieren und die allgemeine Luftqualität in der Umgebung. Als Faustregel gilt jedoch, dass ein HEPA-Filter in einem Saugroboter alle ein bis drei Monate ausgetauscht werden sollte. In Haushalten mit Allergikern, Haustieren oder einer hohen Staubbelastung kann ein häufigerer Wechsel, beispielsweise monatlich, sinnvoll sein.
Viele moderne Geräte erinnern den Nutzer auch über die App an den fälligen Wechsel. Ein verstopfter oder verschmutzter Filter verliert nicht nur seine Effektivität bei der Reinigung der Luft, sondern kann auch die Saugleistung des Roboters beeinträchtigen und den Motor unnötig belasten. Es ist ratsam, stets hochwertige Ersatz-HEPA-Filter zu verwenden, die speziell für das jeweilige Gerätemodell konzipiert sind, um eine optimale Leistung und Filterwirkung zu gewährleisten.
Empfohlene Produkte zu ersatz hepa filter saugroboter

MONSGA Saugroboter mit Wischfunktion, 3.5L Staubsauger Roboter mit Absaugstation

Saugroboter mit Wischfunktion 5000Pa, Staubsauger Roboter 3 in 1 mit 180Min Lauf

dreame D20 Pro Plus Saugroboter, 13.000 Pa Saugkraft, DuoBrush für Tierhaare, Ec

Spino E1 Poolroboter Akku Boden und Wand, 210 Min Kabellos Poolsauger, Max 21950
* Affiliate-Links
Welche Vorteile bieten Saugroboter mit HEPA-Filter für Allergiker?
Für Allergiker sind Saugroboter mit HEPA-Filter ein wahrer Segen und bieten erhebliche Vorteile. Der größte Nutzen liegt in der effektiven Entfernung von Allergenen aus der Raumluft. HEPA-Filter sind so konstruiert, dass sie mindestens 99,97 % aller Partikel mit einer Größe von 0,3 Mikrometern filtern können. Dazu gehören die häufigsten Allergene wie Pollen, Hausstaubmilbenkot, Tierhaare und Schimmelsporen.
Indem der Saugroboter diese Partikel aus der Luft filtert, wird die Allergenbelastung im Haus deutlich reduziert. Dies führt zu einer spürbaren Linderung von Allergiesymptomen wie Niesen, Husten, juckenden Augen oder Atemnot. Zudem können diese Roboter regelmäßig und automatisch reinigen, auch wenn niemand zu Hause ist, was die ständige Aufrechterhaltung einer sauberen und allergenarmen Umgebung ohne direkten Kontakt des Allergikers mit dem Staub ermöglicht. Die verbesserte Luftqualität trägt maßgeblich zum Wohlbefinden und zur Lebensqualität von Allergikern bei.
Empfohlene Produkte zu saugroboter hepa filter

MONSGA Saugroboter mit Wischfunktion, 3.5L Staubsauger Roboter mit Absaugstation

Saugroboter mit Wischfunktion 5000Pa, Staubsauger Roboter 3 in 1 mit 180Min Lauf

dreame D20 Pro Plus Saugroboter, 13.000 Pa Saugkraft, DuoBrush für Tierhaare, Ec

Spino E1 Poolroboter Akku Boden und Wand, 210 Min Kabellos Poolsauger, Max 21950
* Affiliate-Links
Können alle Saugroboter HEPA-Filter verwenden?
Nein, nicht alle Saugroboter sind standardmäßig mit HEPA-Filtern ausgestattet oder können diese nachrüsten. Viele günstigere oder ältere Modelle verwenden einfachere Filter, die zwar groben Schmutz auffangen, aber feine Partikel und Allergene nicht so effizient zurückhalten können wie ein echter HEPA-Filter. Beim Kauf eines neuen Saugroboters sollte man daher explizit auf die Angabe "HEPA-Filter" oder "HEPA-zertifiziert" achten.
Bei einigen Modellen ist es möglich, den Standardfilter durch einen passenden HEPA-Filter als Ersatzteil zu ersetzen, falls der Hersteller dies anbietet. Es ist jedoch wichtig, die Kompatibilität vorab zu prüfen, da die Filter in Größe und Bauart variieren können. Für eine optimale Luftreinigung ist es am besten, ein Modell zu wählen, das von Haus aus für den Einsatz von HEPA-Filtern konzipiert ist und diese auch aktiv bewirbt.
Wie kann ich die Luftqualität in meinem Zuhause zusätzlich verbessern?
Neben dem Einsatz von Saugrobotern mit HEPA-Filtern gibt es weitere effektive Maßnahmen, um die Luftqualität in Ihrem Zuhause signifikant zu verbessern:
- Regelmäßiges Lüften: Stoßlüften für 5-10 Minuten, mehrmals täglich, hilft, verbrauchte Luft auszutauschen und die Konzentration von Schadstoffen zu reduzieren.
- Luftreiniger: Ein dedizierter Luftreiniger mit HEPA-Filter kann die Luft kontinuierlich von Allergenen, Feinstaub und Gerüchen befreien, besonders in Räumen, in denen man sich viel aufhält.
- Luftbefeuchter: Besonders in der Heizperiode kann trockene Luft Atemwege reizen. Ein Luftbefeuchter kann für eine optimale Luftfeuchtigkeit sorgen, die auch die Ausbreitung von Viren hemmen kann.
- Pflanzen: Bestimmte Zimmerpflanzen können zur natürlichen Filterung von Schadstoffen beitragen und das Raumklima verbessern.
- Verzicht auf Rauchen: Rauchen in Innenräumen ist eine der größten Quellen für Feinstaub und schädliche Chemikalien.
- Luftqualitätsmessgeräte: Ein Luftqualitätsmessgerät kann Ihnen helfen, die aktuellen Werte für Feinstaub (PM2.5), CO2 und andere Schadstoffe zu überwachen und bei Bedarf Maßnahmen zu ergreifen.
Durch die Kombination dieser Maßnahmen schaffen Sie ein gesünderes und angenehmeres Wohnklima.
Wie erkenne ich, ob der HEPA-Filter meines Saugroboters ausgetauscht werden muss?
Es gibt mehrere Anzeichen, die darauf hindeuten, dass der HEPA-Filter Ihres Saugroboters gewechselt werden sollte:
- Sichtbare Verschmutzung: Der offensichtlichste Indikator ist, wenn der Filter deutlich verfärbt, grau oder mit einer dicken Staubschicht bedeckt ist. HEPA-Filter sind oft weiß oder hellgrau im Neuzustand.
- Reduzierte Saugleistung: Ein verstopfter Filter behindert den Luftstrom, was zu einer spürbar schlechteren Saugleistung des Roboters führt. Der Roboter nimmt möglicherweise nicht mehr so viel Schmutz auf wie gewohnt.
- Schlechter Geruch: Wenn der Roboter beim Saugen einen muffigen oder staubigen Geruch verbreitet, kann dies ein Zeichen dafür sein, dass sich im Filter Bakterien oder Schimmel angesammelt haben.
- Erhöhte Geräuschentwicklung: Ein verstopfter Filter kann den Motor des Roboters stärker belasten, was sich in einer lauteren Betriebslautstärke äußern kann.
- Meldungen der App: Viele moderne Saugroboter verfügen über eine App, die den Zustand des Filters überwacht und Sie benachrichtigt, wenn ein Wechsel ansteht.
Ignorieren Sie diese Anzeichen nicht, um die Effizienz Ihres Geräts und die Luftqualität optimal zu halten. Halten Sie stets passende Ersatzfilter bereit.
Gibt es Saugroboter, die besonders gut für die Luftreinigung geeignet sind?
Ja, es gibt Saugroboter, die speziell auf eine verbesserte Luftreinigung ausgelegt sind. Diese Modelle zeichnen sich typischerweise durch folgende Merkmale aus:
- Hochwertige HEPA-Filter: Sie sind standardmäßig mit echten HEPA-Filtern ausgestattet, die eine hohe Filterleistung garantieren.
- Versiegelte Systeme: Das Gehäuse des Roboters ist so konstruiert, dass keine ungefilterte Luft entweichen kann.
- Starke Saugleistung: Eine hohe Saugkraft sorgt dafür, dass mehr Staub und Partikel vom Boden aufgenommen werden, bevor sie in die Luft gelangen.
- Kombinierte Wischfunktion: Viele fortschrittliche Modelle bieten zusätzlich eine Wischfunktion. Das feuchte Wischen bindet selbst feinsten Staub, der vom Saugen eventuell nicht erfasst wurde, effektiv an den Boden und verhindert dessen Aufwirbelung. Dies ist besonders effektiv, um die Gesamtmenge an Feinstaub in der Raumluft zu reduzieren.
- Automatische Entleerungsstationen: Modelle mit einer Absaugstation minimieren den Kontakt des Nutzers mit dem gesammelten Staub, was ebenfalls zur Verbesserung der Luftqualität beiträgt, da der Staub nicht manuell in den Mülleimer geschüttelt werden muss.
Achten Sie beim Kauf auf diese Spezifikationen, um ein Gerät zu finden, das optimal zur Verbesserung Ihrer Raumluft beiträgt.
Was ist der Unterschied zwischen einem Standardfilter und einem HEPA-Filter?
Der Hauptunterschied zwischen einem Standardfilter und einem HEPA-Filter liegt in ihrer Filtereffizienz und der Größe der Partikel, die sie zurückhalten können:
- Standardfilter (z.B. Schaumstoff- oder Vliesfilter): Diese Filter sind in vielen grundlegenden Saugrobotern zu finden. Sie sind primär darauf ausgelegt, größere Staubpartikel, Haare und groben Schmutz aufzufangen. Ihre Filtereigenschaften für sehr feine Partikel wie Pollen, Milbenkot, Schimmelsporen oder Feinstaub (PM2.5) sind jedoch begrenzt. Ein Teil dieser Mikropartikel kann durch den Filter entweichen und wieder in die Raumluft geblasen werden. Sie sind oft waschbar und wiederverwendbar, aber ihre Poren sind größer.
- HEPA-Filter: Ein echter HEPA-Filter erfüllt strenge Standards. Er muss mindestens 99,97 % aller Partikel mit einer Größe von 0,3 Mikrometern (µm) filtern. Diese Partikelgröße ist besonders schwer zu filtern und repräsentiert viele der schädlichsten Allergene und Feinstäube. HEPA-Filter bestehen aus einem feinen, dichten Fasernetz, das Partikel durch drei Mechanismen (Impaktion, Interzeption und Diffusion) einfängt. Aufgrund ihrer hohen Effizienz sind sie ideal für Allergiker und zur Verbesserung der allgemeinen Luftqualität. Sie sind in der Regel nicht waschbar, da dies ihre feine Struktur beschädigen und die Filterleistung mindern würde. Regelmäßiger Austausch mit neuen HEPA-Filtern ist hier entscheidend.
Kurz gesagt: HEPA-Filter bieten einen deutlich höheren Schutz vor Mikropartikeln und Allergenen als Standardfilter.